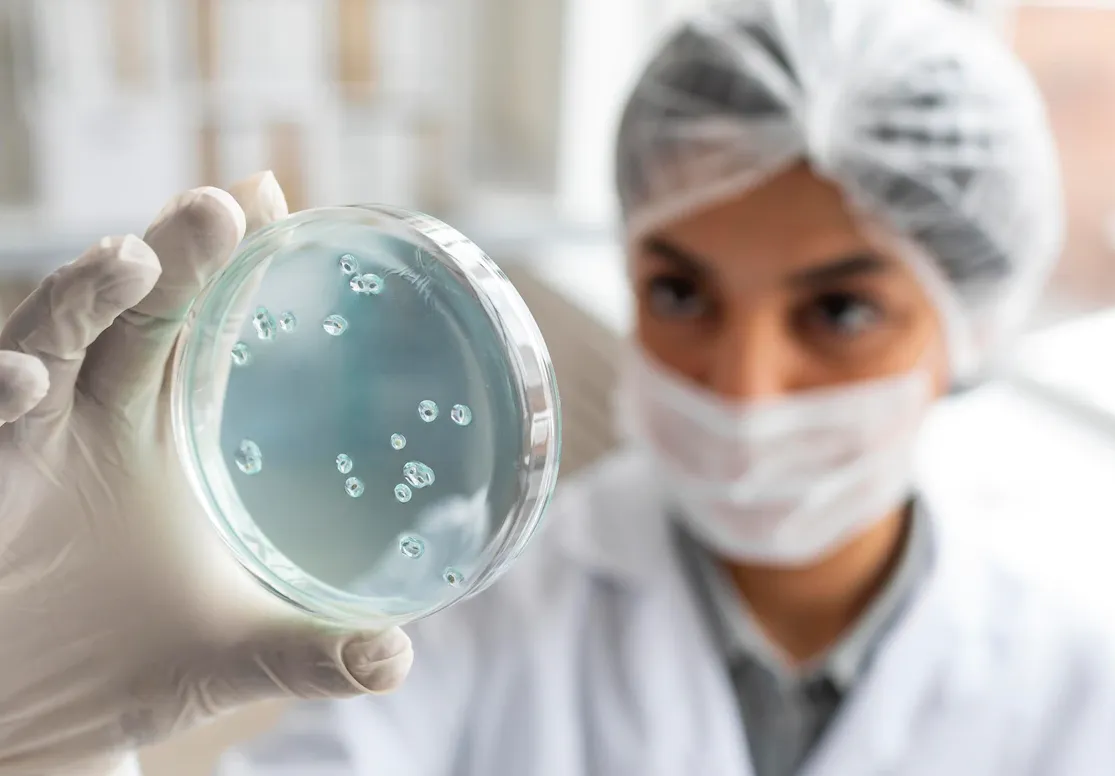

Laboratorio Ambiental
Laboratorio de pruebas ambientales
En INGENIA CONSULTORES Y SERVICIOS AMBIENTALES, ofrecemos soluciones integrales en nuestra división de Laboratorio de Pruebas Ambientales. Nos dedicamos a llevar a cabo rigurosos estudios de Laboratorio, asegurando la sustentabilidad y el cumplimento normativo en todos sus proyectos.
Contacto e Información
Su confianza y el cuidado del medio ambiente son nuestra prioridad. Confíe en nosotros para acompañarle en su próximo proyecto ambiental con la certeza de que está contribuyendo al bienestar del planeta.
Nuestros análisis están respaldados con la acreditación ante la EMA, CONAGUA y métodos internos de nuestro sistema de Gestión de Calidad.